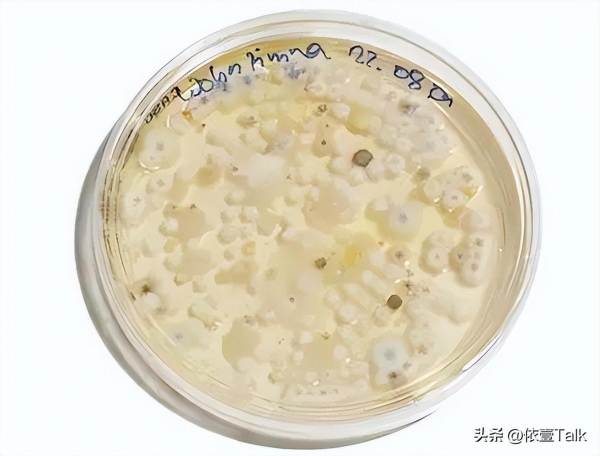

在夏天,人们往往会因为天气炎热,导致没有胃口,这时就有人会选择吃一碗凉皮,放点辣椒,放点醋,酸辣爽口还解暑,深受人们喜欢。

可是也就是这深受人们喜欢的一种食物,却也成为了致人死亡的原因。
2023年7月23日,河南永城两名女子,因吃凉皮导致中毒,后1死1伤,经检测两人是米酵菌酸中毒。

凉皮里的毒素!
米酵菌酸毒素是一种长链脂肪酸结构的细菌毒素,是唐菖蒲伯克霍尔德氏菌,又称椰毒假单胞菌米面亚种,产生的具有剧毒的一种毒素。

这种毒素,通常会出现在谷类发酵制品、变质淀粉类制品、变质的银耳和木耳,它们产生米酵菌酸毒素都有一个共同的特点。
它们在制作时都需要潮湿的环境,这时它们就被充当"培养皿"的作用,给唐菖蒲伯克霍尔德氏菌提供合适的生存环境,大量产生具有剧毒的米酵菌酸。
唐菖蒲伯克霍尔德氏菌在自然界中大量存在,它最适宜环境的温度是25~37摄氏度,也喜欢潮湿的环境。
它的稳定性很强,耐热性也很强,甚至高温高压的情况下,都不能破它的毒性,而且它还无色无味,从而导致米酵菌毒素中毒的风险大大增加。

米酵菌酸毒素中毒后,并不会立马显现出来,它潜伏期一般为半个小时至12小时,有少数人潜伏期为24至48小时。
米酵菌酸毒素被认定为剧毒,中毒后常会对肝、肾、脑、心、肺等造成影响,主要表现为上腹部不适、恶心、呕吐、腹泻、头晕和浑身无力。

严重时可能会发生咖啡色状呕吐物,尿血,吐血、惊厥、休克,也会出现身体多器官功能丧失机能,最终直至死亡。
并且米酵菌酸目前没有能够解毒的特效药,只需要1毫克的量,就会导致人死亡,所以在人们中毒后的死亡率极高,致死率甚至超过了50%。

如果在日常生活中,怀疑自己米酵菌酸中毒了,要立即停止食用,催吐自己,尽可能的将自己吃的都吐出来,以免吸收过多的毒素,并且及时就医。
中毒事件也曾多次发生
2024年6月,我国台湾省就曾发生一起食物中毒案,共导致6人死亡,只有1人出院,据当地部门经对尸体的解剖分析,确认检测出有毒物质米酵菌酸的成分。

2020年10月,黑龙江一家庭用谷类食材,发酵自制"酸汤子",食用后9人全部死亡,同样也是因为米酵菌酸毒素导致死亡。

2020年8月广东也发生了一起食用肠粉导致食物中毒的事件,罪魁祸首依然是米酵菌酸毒素。

2020年7月广东也发生了一起食用河粉导致食物中毒的事件,最终共导致11人中毒,1人死亡,罪魁祸首依然是米酵菌酸毒素。
米酵菌酸毒素的预防
米酵菌酸毒素中毒主要是食材被唐菖蒲伯克霍尔德氏菌污染导致的,那该如何避免产生米酵菌酸毒素呢?
家庭要避免自制发酵米面食物,因为环境不可控,唐菖蒲伯克霍尔德氏菌的生存能力有很强,所以在自制时,容易造成,食物的污染,从而导致米酵菌酸毒素的产生。

所以我们最好选择合法合规的厂家,并且生产时期、保质期都在时间内,保存条件等,选择条件都符合的去购买。
这类食品的保质期一般为24小时,我们在购买时,要尤其注意商品的生产日期保质期。

因为变质淀粉类食品即使过期了,它们的感官性状依然正常,依旧保持着无色无味的性状,让人们难以察觉,从而导致中毒的风险增加。
在泡发木耳前一定要检查一下,如果出现受潮,腐烂和霉变的木耳,一定不要食用,不要存在侥幸心理,在购买时就要少买多次,即吃即用,做到最安全。

泡发过程中,如果用冷水泡发木耳,建议泡发时间为1-2小时,最多不超过4小时,如用温水泡发,建议在制备餐食前半小时泡发即可,避免长时间的泡发,导致米酵菌酸毒素的产生。
这些食物要做到即做即吃,因为放冰箱里时间长了,同样可能会产生米酵菌酸毒素。

该如何储存这些食材呢?
在储存这些食品时,要做到干燥通风、阳光直射避免高温高湿的环境,并且避免与外物接触,如果发现这些食材有的已经发生性状改变,一定要扔掉,不可食用。

再次提醒,如果疑似发生食物中毒,应立即停止对该,尽快催吐,排出胃内容物,以减少毒素的吸收和对机体的损伤,并及时送医院救治,对症治疗。
这些食材本身是没有毒的,是处理不得当,才导致细菌的滋生,从而使食物有了毒性,发芽的马铃薯,未成熟的番茄这类食物中毒的案例,也经常发生。

但是如果处理得当,即使是剧毒的河豚,也能成为餐桌上的一顿美食,所以在做美食时,一定要处理得当。
夏天多雨且天气炎热,食物最容易变质,我们在注意米酵菌酸毒素时,同时也要注意变质食物带来的危害,不要存在侥幸心理,如果有问题,请及时就医,避免发生悲剧。










